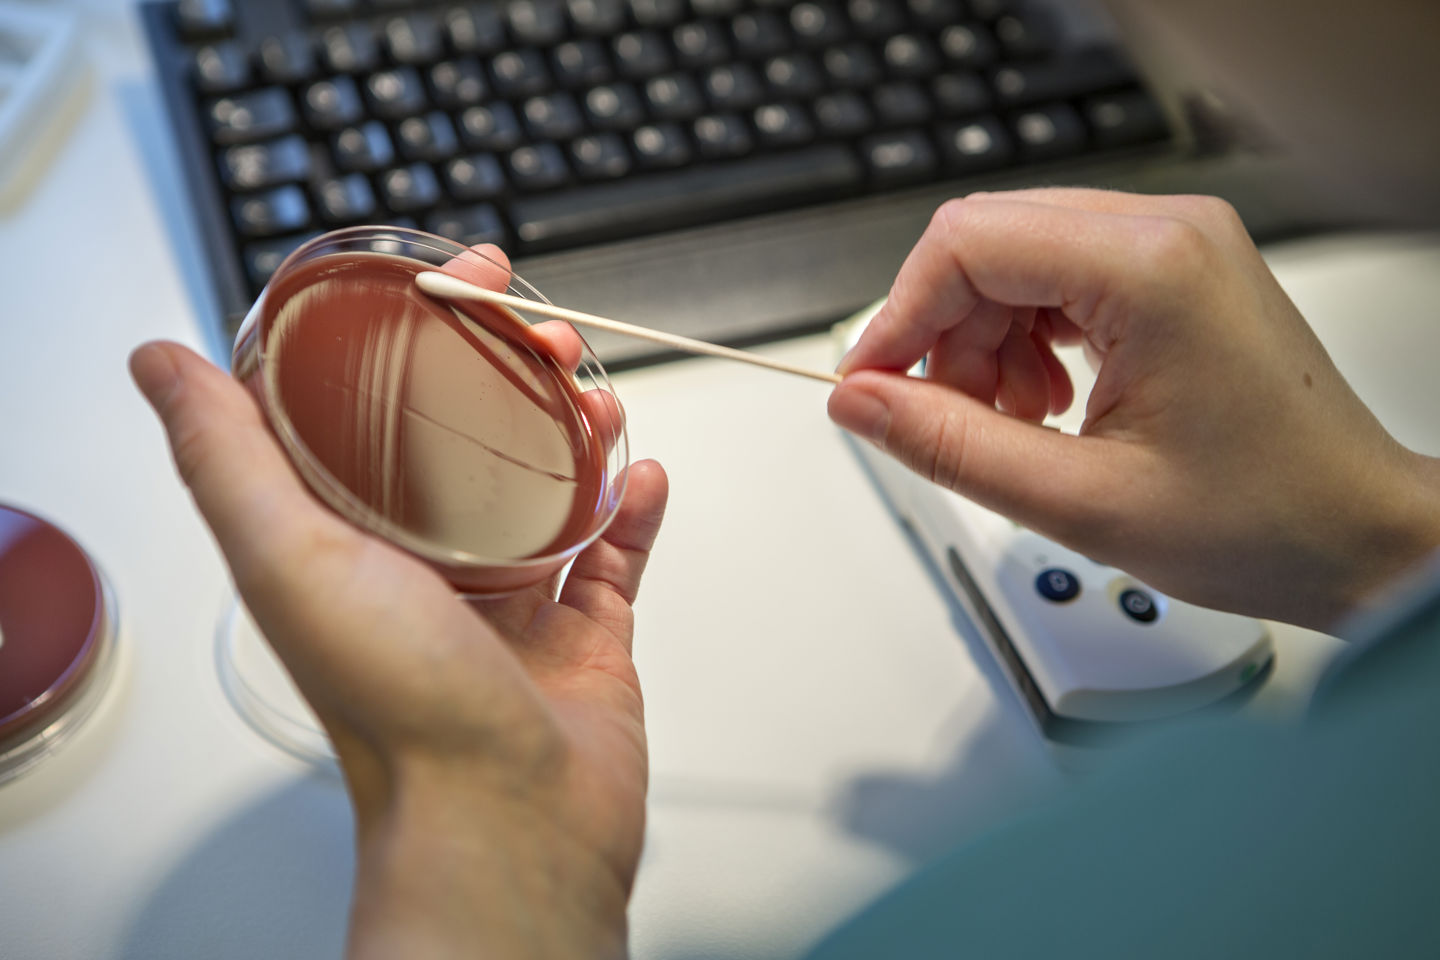
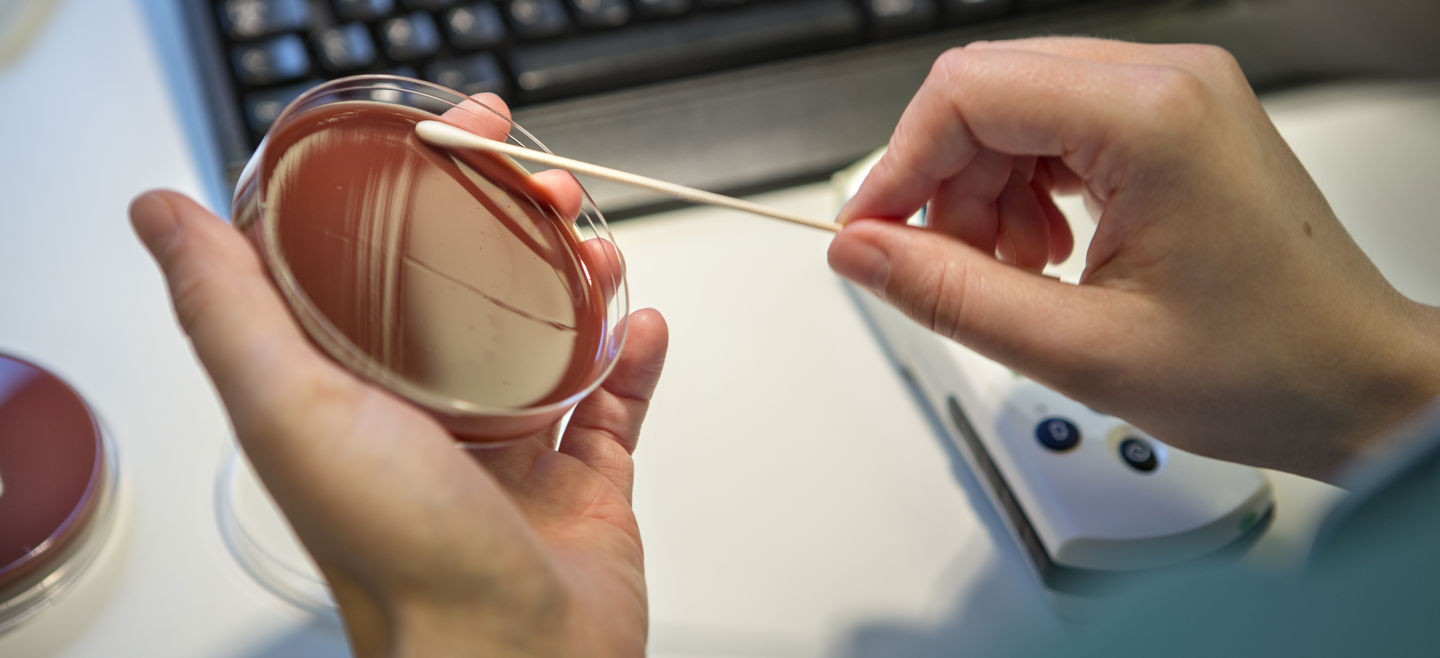

VIVE opstiller scenarier for, hvordan de mest effektive digitale sundhedsløsninger kan udpeges
Undersøgelsens deltagere:
Sundhed
Økonomi og styring
Sundhed, Økonomi og styring
Apps, der hjælper patienter med at tage medicin til tiden; kunstig intelligens, der kan hjælpe med at stille diagnoser; telemedicinske platforme, hvor patienter følges på afstand.
Digitale sundhedsløsninger kan skabe nye muligheder for behandling af patienter og udnyttelse af ressourcerne i sundhedsvæsenet. Samtidig kan det være en udfordring for beslutningstagere at afgøre, hvilke teknologier der skal tages i brug.
Sundhedsvæsenet har kun et begrænset antal læger, sygeplejersker og sengepladser, og ikke alle behandlinger virker lige godt for alle. Beslutningstagere skal derfor tage stilling til, hvordan ressourcerne fordeles så effektivt som muligt, herunder prioritere de digitale sundhedsløsninger, som er virksomme og effektive.
I et nyt projekt undersøger VIVE erfaringer fra andre europæiske lande og opstiller forskellige scenarier for, hvordan arbejdet med at vurdere effekten af digitale sundhedsløsninger og finansiere disse kan organiseres.
Metoder
Analysen tager udgangspunkt i erfaringer fra tre forskellige lande: England, Frankrig og Tyskland. Analysen vil beskrive landenes organisatoriske setup for, hvordan der udarbejdes effektevalueringer af digitale sundhedsløsninger, og hvordan anbefalinger eller beslutninger, som følges af disse evalueringer, efterfølgende implementeres og finansieres.
Fokus er på at beskrive samt belyse muligheder og opmærksomhedspunkter ved forskellige organiseringer. Analysen baseres blandt andet på gennemgang af eksisterende litteratur og interviews med videnspersoner i de lande, som er omfattet af analysen.
Undersøgelsens deltagere
Projektleder
Projektmedarbejdere
Om denne undersøgelse
Finansieret af
Indenrigs- og SundhedsministerietSamarbejdspartnere
Projektet samarbejder med Professor Kristian Kidholm, CIMT – Center for Innovativ Medicinsk Teknologi.